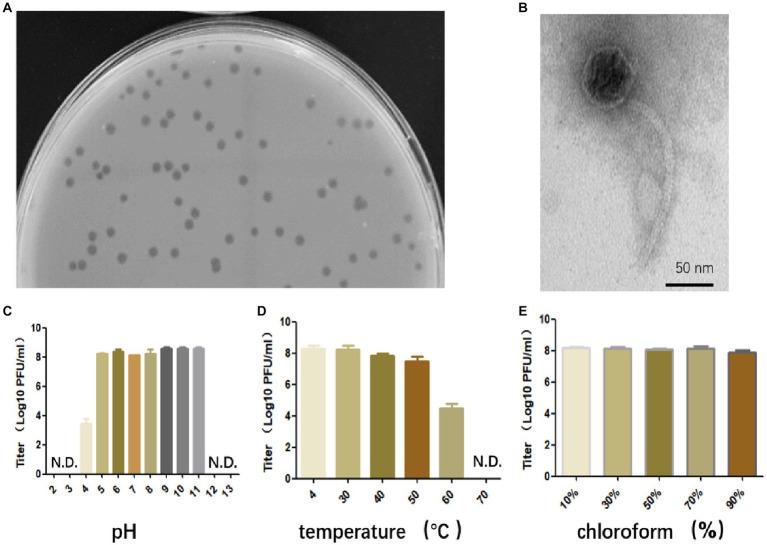
https://cdn.ncbi.nlm.nih.gov/pmc/blobs/3e37/10324664/fc86f1e16bf4/fmicb-14-1210319-g001.jpg

一种噬菌体SFQ1作为潜在治疗剂的特性研究。 (注:原文中“an bacteriophage”表述有误,应为“a bacteriophage”)
Characterization of an bacteriophage SFQ1 as a potential therapeutic agent.
作者信息
Song Fuqiang, Sheng Jun, Tan Jishan, Xie Huajie, Wang Xiaoyu, Guo Wenqiong
机构信息
Department of Medical Laboratory, The General Hospital of Western Theater Command, Chengdu, China.
Department of Orthopaedics, The General Hospital of Western Theater Command, Chengdu, China.
出版信息
Front Microbiol. 2023 Jun 22;14:1210319. doi: 10.3389/fmicb.2023.1210319. eCollection 2023.
is a well-established resident of the human gastrointestinal tract and is also a major cause of human infections. Unfortunately, therapeutic options for infections remain limited, particularly with the emergence of vancomycin-resistant strains in hospital settings. Consequently, there has been a renewed interest in phage therapy as an alternative to antibiotics. In this study, we have isolated a bacteriophage, vB_EfaS-SFQ1, from hospital sewage, which effectively infects strain EFS01. Phage SFQ1 is a siphovirus and exhibits a relatively broad host range. Furthermore, it has a short latent period of approximately 10 min and a large burst size of about 110 PFU/cell at a multiplicity of infection (MOI) of 0.01, and it could effectively disrupt the biofilms formed by . Thus, this study provides a detailed characterization of phage SFQ1, which has great potential for treating infections.
是人类胃肠道中一种常见的微生物,也是人类感染的主要原因。不幸的是,针对感染的治疗选择仍然有限,尤其是在医院环境中出现耐万古霉素菌株的情况下。因此,作为抗生素的替代方法,噬菌体疗法重新引起了人们的兴趣。在本研究中,我们从医院污水中分离出一种噬菌体vB_EfaS-SFQ1,它能有效感染EFS01菌株。噬菌体SFQ1是一种长尾噬菌体,具有相对较宽的宿主范围。此外,在感染复数(MOI)为0.01时,它的潜伏期较短,约为10分钟,裂解量较大,约为110 PFU/细胞,并且它能有效破坏由形成的生物膜。因此,本研究对噬菌体SFQ1进行了详细的表征,其在治疗感染方面具有巨大潜力。